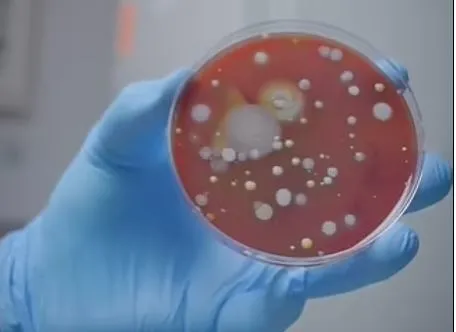
el-kurutma-makinelerindeki-dehset-ellerinizi-bir-bakteri-yuvasina-donusturuyor-hic-yikanmamis-gibi-1661502321453.jpg

Lewis, benzin isyasyonu, sinema salonu ve mağazalardaki el kurutma makinelerinin altına doğru petri kaplarını birkaç saniye bekletti. 13 gün boyunca kuluçkaya yatırdığı bu kapları incelediğinde beyaz, sarı ve siyah lekeler halinde görünen bakteri ve mantarlarla dolu olduğunu tespit etti. Bu nedenle halka açık tuvaletlerdeki el kurutma makinelerinin tehlikesine dikkat çekti.
Bu deneyi TikTok kanalında yayınlayan Lewis, sonuçların beklediğinden çok daha kötü olduğunu açıklarken diğer yüzeylerin de muhtemel olarak çok daha kötü bir bakteri istilasında olduğunu belirtti.

"BU DENLİ ŞİDDETLİ OLMASI BEKLENMİYORDU"
50 yıllık bir mikrobiyolog olan Dr. David Webber de yaptığı açıklamada, tuvaletten sonra ellerinizi yıkamanızın ardından bu makinelerde kurutmanın aslında bakterilerin yeniden ellerinize yerleşmesine neden olmak olduğunu söyledi.
Lewis, sonuçların bakterilerin varlığının pozitif olacağını tahmin ettiğini ancak sonucun bu denli şiddetli seviyede olacağını tahmin etmediğini belirtti.
Daha önce kurutucularda hangi bakteri ve mantarların gizlendiğini belirlemek için hiçbir test yapılmadı ve araştırmacılar, elleri kağıt havluyla kurutmanın etkilerini araştırmadı. Ancak önceki araştırmalar, el kurutma makinelerinin, etraflarındaki havayı emdiklerinde mikroorganizmaların varlığını sürdürebileceği alanlardan biri olarak, insanların ellerine bakterileri yeniden yerleştirebileceğini öne sürdü.
"KENDİ KURUTMA MENDİLLERİNİZİ TAŞIYABİLİRSİNİZ"
Testler ayrıca el kurutma makinelerinin ağızlarında gizli bakteri kolonilerini ortaya çıkardı. Uzmanlar, ellerinizi yıkadıktan sonra kurutmanın çok önemli olduğunu söylüyor çünkü birçok bakteri türü sıcak ve nemli yerlerde üremeyi seviyor.

E.coli gibi gıda zehirlenmesine neden olabilen bakteriler, eller de dahil olmak üzere nemli yüzeylerde gelişir. Önceki araştırmalar, yüzeyleri kirleten insanlar tarafından yayılan mikropların yüzde 85'inin eller hala nemliyken ortaya çıktığını öne sürmüştü. Ancak ellerinizi kurutmanın havlu kullanımı gibi birbirinden farklı kurutma yöntemi bulunuyor.
Açık alanlardaki kurutma makineleri yerine kendinize ait bir kağıt mendil taşıyarak ellerinizi yıkadıktan sonra kurutmanız, çok daha hijyenik ve sağlıklı bir seçenek olabilir.